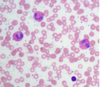

Mitä solujen erilaistumisella tarkoitetaan?
Solujen erilaistumisessa alkuperäiset, monipuoliset alkiosolut erikoistuvat erilaisiin tehtäviin ja muuttuvat eri kudosten ja elinten muodostaviksi soluiksi. Tämä erilaistuminen tapahtuu erilaistumisproteiinien ja geenien säätelyn avulla, jotka ohjaavat solujen toimintaa ja muuttavat niiden rakennetta ja toimintoja.
Esimerkkejä solujen erilaistumisesta ovat verisolujen erilaistuminen punasoluiksi, valkosoluiksi ja verihiutaleiksi, sekä epidermiksen solujen erilaistuminen ihon pintasoluiksi, karvatupen soluiksi ja hikirauhasen soluiksi.
Mitkä ovat ihmisen pääkudostyypit?

Miten solut viestivät, ja mitä on homeostaasi?

Millainen on luuston rakenne, ja mitä tehtäviä luustolla on?

Millainen rakenne eri lihassolutyypeillä on, ja mitä tehtäviä lihaksilla on?
Poikkijuovainen lihas (skelettilihas):
Rakenne: Poikkijuovainen lihas koostuu pitkistä monitumaisista soluista, jotka ovat nimeltään lihassyyt. Lihassyyt ovat rakenteeltaan pitkiä ja putkimaisia, ja niiden sisällä on runsaasti sarkomeereiksi kutsuttuja supistumiskykyisiä yksiköitä. Näiden sarkomeerien vuorottelu antaa lihakselle poikkijuovan ulkonäön.
Tehtävät: Poikkijuovaiset lihakset vastaavat tahdonalaisesta liikkeestä ja liikkumisesta. Ne kiinnittyvät luuhun jänteiden avulla ja toimivat yhteistyössä hermoston kanssa tuottaen liikettä ja voimaa kehon eri osiin. Skelettilihakset myös ylläpitävät kehon asentoa ja tukevat luurankoa.
Sileä lihas:
Rakenne: Sileät lihassolut ovat pitkiä ja ohuita, eivätkä ne näytä poikkijuovaisilta kuten skelettilihassolut. Ne koostuvat yhdestä ytimettömästä solusta, joka on kiertynyt yhteen pitkäksi kuiduksi. Sileissä lihassoluissa ei ole sarkomeereja, ja niiden supistumiskyky perustuu erilaisiin mekanismeihin kuin poikkijuovaisissa lihaksissa.
Tehtävät: Sileät lihakset sijaitsevat monissa sisäelimissä, kuten suolistossa, verisuonissa, virtsarakossa ja keuhkoputkissa. Niiden tehtävänä on säädellä ja ylläpitää sisäelinten toimintaa, kuten ruoansulatusta, verenkiertoa, virtsaneritystä ja hengitystä.
Sydänlihas:
Rakenne: Sydänlihassolut muodostavat sydämen seinämän ja ovat haaroittuneita, haarautuvia ja poikkijuovaisia. Ne sisältävät monia sarkomeereja, kuten poikkijuovaiset lihassolut, mutta ovat keskenään yhdistyneitä ja muodostavat toiminnallisia yksiköitä, jotka kutsutaan sydämen soluverkostoksi.
Tehtävät: Sydänlihas vastaa sydämen supistumisesta ja veren pumpusta kehon läpi. Se toimii tahdosta riippumattomasti ja jatkuvasti ylläpitäen verenkiertoa ja hapensaantia kaikille kehon soluille.
Poikkijuovaisen lihassolun supistuminen

Poikkijuovaisten lihassolujen energiatalous

Sydänlihaskudos


Sileä lihaskudos

Ohuita lihaskerroksia sisäelimissä
Ruuansulatuskanavan, kohdun, virtsarakon sekä valtimoiden ja laskimoiden seinämässä
Hengitysteissä, ihon karvankohottajalihaksissa, silmän iiriksessä ja sädelihaksessa
Solut lyhyitä, sukkulamaisia, yksitumaisia
Aktiinia ja myosiinia, mutta ei sarkomeereina
Solut supistuvat hitaasti, väsymättä ja tahdosta riippumatta eli autonomisesti
Autonominen hermosto ja tietyt hormonit voivat sekä lisätä että vähentää solujen supistusastetta









Side- ja tukikudos

Side- ja tukikudos on kudosryhmistä monimuotoisin. Useimmissa side- ja tukikudostyypeissä on runsaasti soluväliainetta. Soluväliaineen tärkeimpiä proteiineja on kollageeni.
Sidekudos
Löyhää sidekudosta esimerkiksi ihossa ja verisuonten ympärillä
Tiivistä sidekudosta jänteissä ja siteissä sekä elimiä ympäröivissä kalvoissa
Luukudos
Tukirangassa
Koostuu erilaisista luusoluista ja kalsiumfosfaattia sekä kollageenia ja kalsiumia sisältävästä kovasta soluväliaineesta
Rustokudos
Tukirangassa
Luukudosta joustavampaa
Koostuu rustosoluista sekä hiilihydraatteja ja proteiineja sisältävästä soluväliaineesta
Rasvakudos
Ihonalaiskerroksessa ja sisäelinten ympärillä
Suoja, elimistön energiavarasto
Normaalipainoisen aikuisen ihmisen kehon painosta 10–25 prosenttia on rasvakudosta
Koostuu rasvasoluista, ei juuri soluväliainetta
Soluissa rasvaa joko suurena yhtenäisenä pisarana (valkoinen rasvasolu) tai pieninä erillisinä pisaroina (ruskea rasvasolu)
Veri

Pinta- eli epiteelikudos












Selitä, miten rakenteet 4, 5 ja 7 osallistuvat käden koukistamiseen.

Hauislihaksen supistuessa värttinäluu liikkuu kohti lapaluuta. Kolmipäinen olkalihas on tuolloin levossa (rentoutuneena). Nivelrusto ja nivelneste suojelevat pitkien luiden päitä kulumiselta.


Millaiset luustolihaksen lihassolut ovat tarpeellisia? A) pikajuoksijoille, B) maratoonareille?
A)Pikajuoksija hyötyy nopean tyypin lihassoluista (maitohappokäyminen)
B)Maratoonareille taas hitaan tyypin lihassolut sopivat parhaiten (soluhengitys)
Milloin lihassoluihin syntyy maitohappoa ja miten elimistö poistaa sen?
Kun lihassolut eivät kovassa rasituksessa saa riittävästi happea, tapahtuu maitohappokäyminen. Maitohappoa kertyy lihakseen. Tämä aiheuttaa happamuuden muutoksen, ja lihas väsyy.
Syntynyt maitohappo siirtyy lihaksista verenkierron mukana maksaan, jossa osa maitohaposta muutetaan entsyymien avulla glukoosiksi.